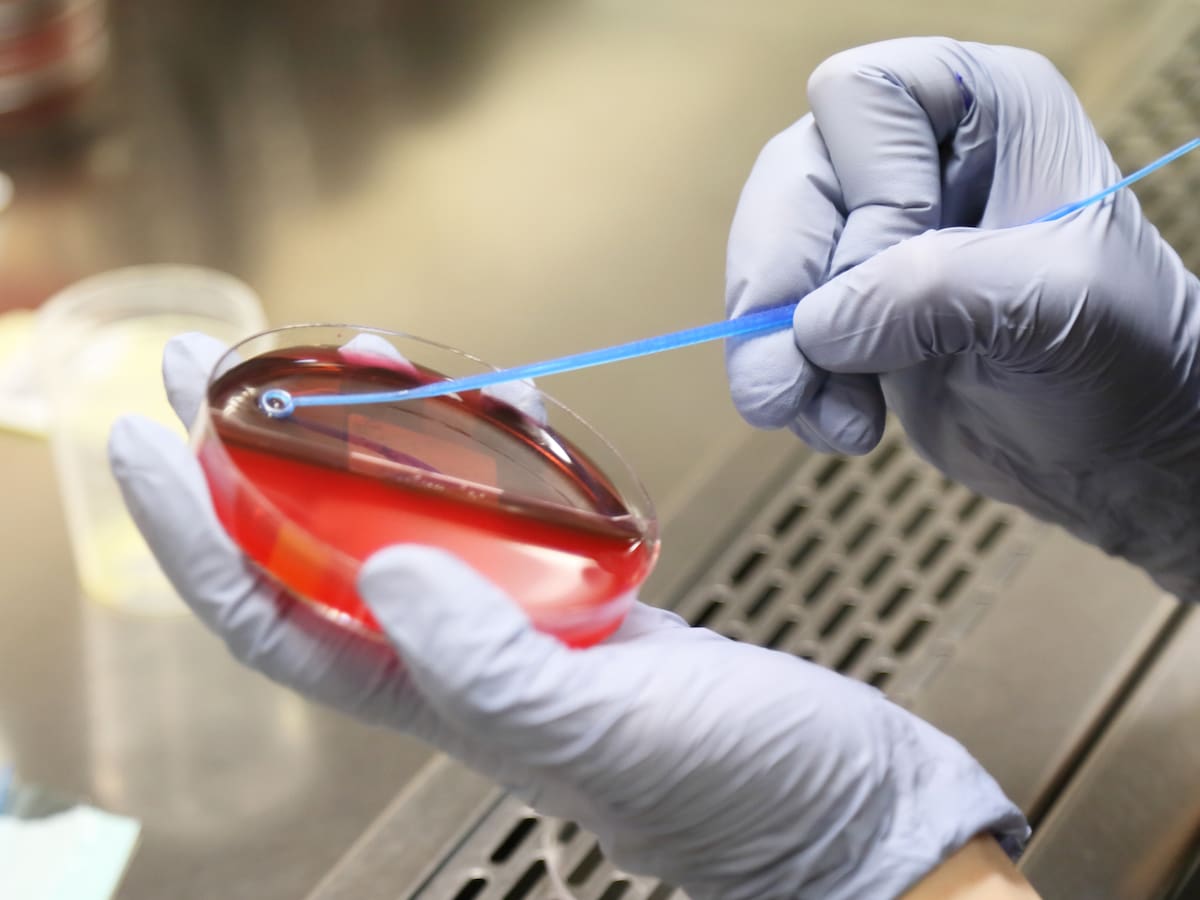

Vinculan el incendio originado tras varias explosiones esta madrugada en el Torrejón, sin heridos, con los últimos episodios violentos en el barrio
La Policía Nacional recibió varias llamadas alertando sobre una serie de explosiones y el posterior incendio en el edificio de la plaza Violeta del barrio onubense
25/10/2024 - 10:18
Santiago González Sarrión
Huelva